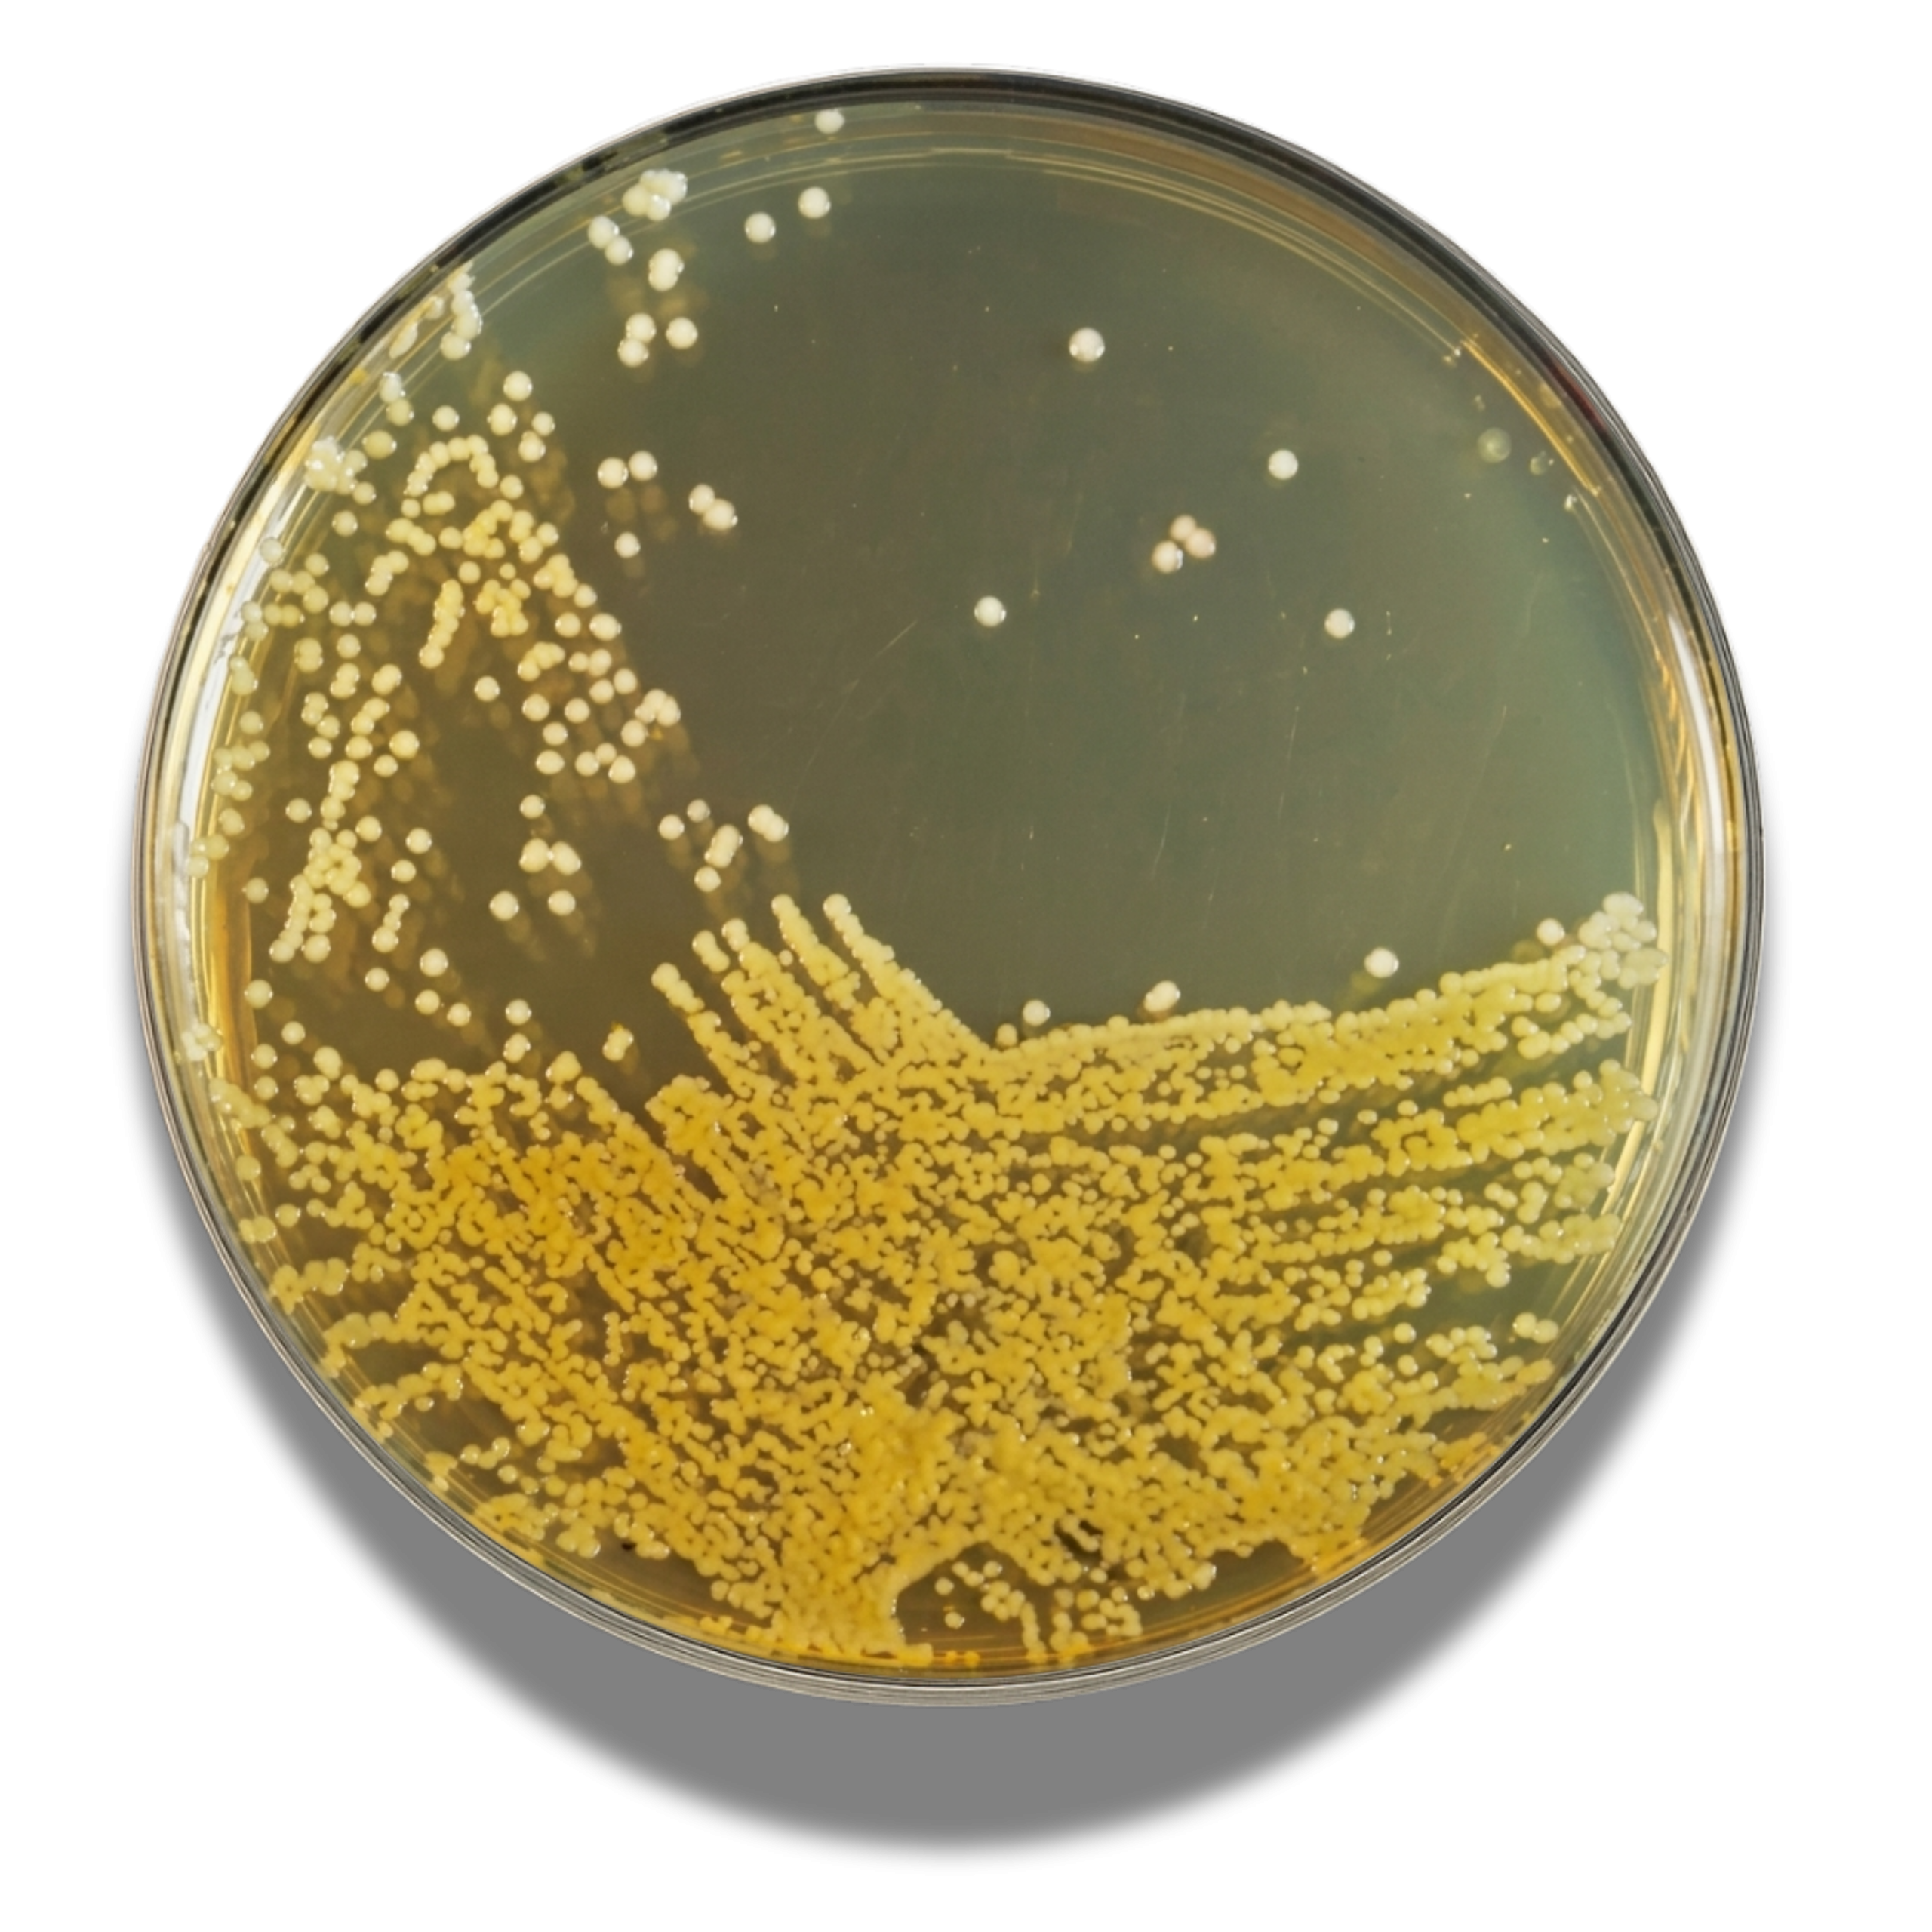

- Wishlist
- SKU : 4012352
- 500 g
Additional Info
| Brand |
BioLife |
|---|
In vitro diagnostic. General purposes medium for the cultivation and maintenance of fastidious and non fastidious microorganisms, from a variety of clinical and nonclinical specimens.
Be the first to review “BRAIN HEART INFUSION AGAR” Cancel reply
You must be logged in to post a review.
Reviews
There are no reviews yet.